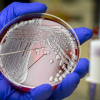

Beber vinho faz bem para a saúde?
Veja o que especialistas dizem sobre o consumo da bebida

Veja o que especialistas dizem sobre o consumo da bebida

Apenas o Distrito Federal e quatro estados não relataram casos da doença

Planta usada como tempero é rica em nutrientes importantes à saúde

Saber identificá-los pode ajudar a combater as causas da reação





Naturalista e Iridólogia vai estar na Mais Natural neste sábado, dia 17 de agosto

Entre as alergias mais comuns, rinite afeta 82% dos entrevistados em estudo

Dados foram divulgados nesta terça-feira pelo Ministério da Saúde

Entenda o que é a doença que está preocupando o Brasil





Falta de orientação e busca por resultados rápidos levam a escolhas inadequadas

Existem mais de 300 causas de queda de cabelo, mas esses produtos só ajudarão em alguns casos

Veja a melhor alternativa para quem deseja emagrecer

Maioria dos brasileiros descobre doenças relacionadas tardiamente